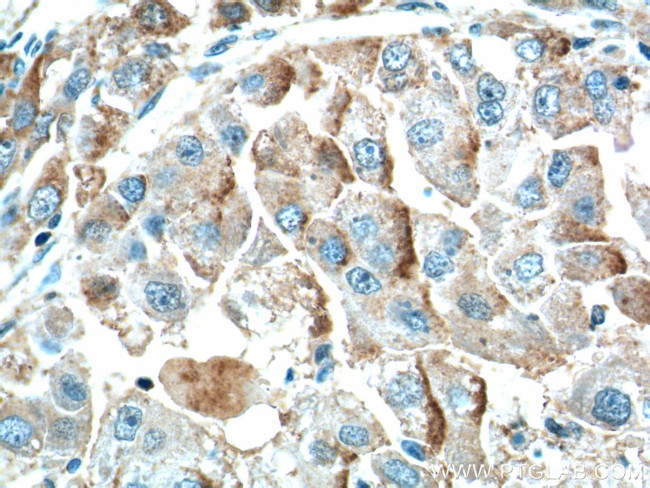
ZIP4 Antibody in Immunohistochemistry (Paraffin) (IHC (P))

Search
Proteintech
ZIP4 Polyclonal Antibody
{{$productOrderCtrl.translations['antibody.pdp.commerceCard.promotion.promotions']}}
{{$productOrderCtrl.translations['antibody.pdp.commerceCard.promotion.viewpromo']}}
{{$productOrderCtrl.translations['antibody.pdp.commerceCard.promotion.promocode']}}: {{promo.promoCode}} {{promo.promoTitle}} {{promo.promoDescription}}. {{$productOrderCtrl.translations['antibody.pdp.commerceCard.promotion.learnmore']}}
产品信息
20625-1-AP
种属反应
已发表种属
宿主/亚型
分类
类型
抗原
偶联物
形式
浓度
规格
纯化类型
保存液
内含物
保存条件
运输条件
产品详细信息
Immunogen sequence: SPPAGLLSL LTSGQGALDQ EALGGLLNTL ADRVHCTNGP CGKCLSVEDA LGLGEPEGSG LPPGPVLEAR YVARLSAAAV LYLSNPEGTC EDTRAGLWAS HADHLLALLE SPKALTPGLS WLLQRMQARA AGQTPKTACV DIPQLLEEAV GAGAPGSAGG VLAALLDHVR SGSCFHALPS PQYFVDFVFQ QHSSEVPMTL AELSALMQRL GVGREAHSDH SHRHRGASSR DPVPLISSSN SSSVWDTVCL SARDVMAAYG LSEQAGVTPE AWAQLSPALL QQQLSGACTS QSRPPVQDQL SQSERY (23-327 aa encoded by BC062625)
靶标信息
The zinc transporter ZIP4, also known as SLC39A4, is a member of a family of divalent ion transporters. Zinc is an essential ion for cells and plays significant roles in the growth, development, and differentiation. ZIP4 was initially identified as zinc-uptake transporter in the intestine and as a candidate gene for acrodermatitis enteropathica (AE), a rare inherited defect in the absorption of dietary zinc. Similar to other ZIP family members, aberrant expression of ZIP4 has been linked to cancer, specifically the progression and aggressiveness of pancreatic cancer. ZIP4 expression has also been shown to be activated in hepatocellular carcinomas, acting to repress apoptosis, enhance cell cycle and increase migration, suggesting ZIP4 may play a role in multiple types of cancers.
仅用于科研。不用于诊断过程。未经明确授权不得转售。
生物信息学
蛋白别名: Activated in W/Wv mouse stomach 2; mAWMS2; solute carrier family 39 (zinc transporter) member 4 isoform SLC39A4_1; solute carrier family 39 (zinc transporter) member 4 isoform SLC39A4_2; solute carrier family 39 (zinc transporter), member 4; Solute carrier family 39 member 4; unnamed protein product; zinc transporter 4; Zinc transporter ZIP4; ZIP-4; Zrt- and Irt-like protein 4; ZRT/IRT-like protein 4
基因别名: 1600025H15Rik; AEZ; AU041686; AWMS2; SLC39A4; ZIP4
UniProt ID: (Human) Q6P5W5, (Mouse) Q78IQ7
Entrez Gene ID: (Human) 55630, (Mouse) 72027